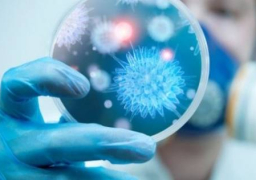
الصحة: رفع درجة الاستعداد القصوى بمنافذ دخول البلاد لمنع تسلل أى فيروسات أو أمراض وبائية

اخبار رئيسية
بن زايد :مهرجان شرم الشيخ التراثى يجسد عمق الروابط الاخوية والتاريخية
قال الشيخ محمد بن زايد ولى عهد أبوظبي، نائب القائد الأعلى للقوات المسلحة إن مهرجان شرم الشيخ يعد ملتقى يجسد موروثنا الشبعى الاصيل وعمق الروابط الاخوية والتاريخية التى تجمع...
إقرأ المزيدالسيسى يشيد بلقاء محمد بن زايد فى افتتاح مهرجان شرم الشيخ التراثى
اكد الرئيس عبد الفتاح السيسي سعادته بلقاء اخيه سمو الشيخ محمد بن زايد وإطلاق فعاليات مهرجان شرم الشيخ التراثي مؤكدا عمق أواصر الصداقة والمحبة الدائمة التي تجمع بين الشعبين...
إقرأ المزيدالسيسي وولي عهد أبو ظبي يفتتحان مهرجان شرم الشيخ التراثي العربي
افتتح الرئيس عبد الفتاح السيسي رئيس الجمهورية ، وولي عهد أبو ظبي الشيخ محمد بن زايد آل نهيان ، اليوم الخميس، مهرجان شرم الشيخ التراثي العربي “سباق الهجن الدولي”...
إقرأ المزيدالصحة: رفع درجة الاستعداد القصوى بمنافذ دخول البلاد لمنع تسلل أى فيروسات أو أمراض وبائية
بعد تحذيرات منظمة الصحة العالمية من انتشار فيروس غامض.. الصحة: رفع درجة الاستعداد القصوى بمنافذ دخول البلاد لمنع تسلل أى فيروسات أو أمراض وبائية أعلنت وزارة الصحة والسكان، عن...
إقرأ المزيدبالصور..تواصل فعاليات مبادرة “كلنا واحد “لتوفير السلع بأسعار مخفضة
تتواصل فعاليات المرحلة الحادية عشر من مبادرة “كلنا واحد” التي انطلقت أمس بكافة مديريات الأمن على مستوى الجمهورية لتوفير السلع الأساسية وطرحها بعدد كبير من فروع كبرى السلاسل التجارية...
إقرأ المزيدصحف الامارات: افتتاح “قاعدة برنيس” شاهد على عمق العلاقات بين البلدين
أكدت صحف الإمارات, في افتتاحياتها اليوم /الخميس/, أن مشاركة الشيخ محمد بن زايد آل نهيان, ولي عهد أبوظبي, نائب القائد الأعلي للقوات المسلحة في افتتاح “قاعدة برنيس” بالمنطقة الجنوبية...
إقرأ المزيد